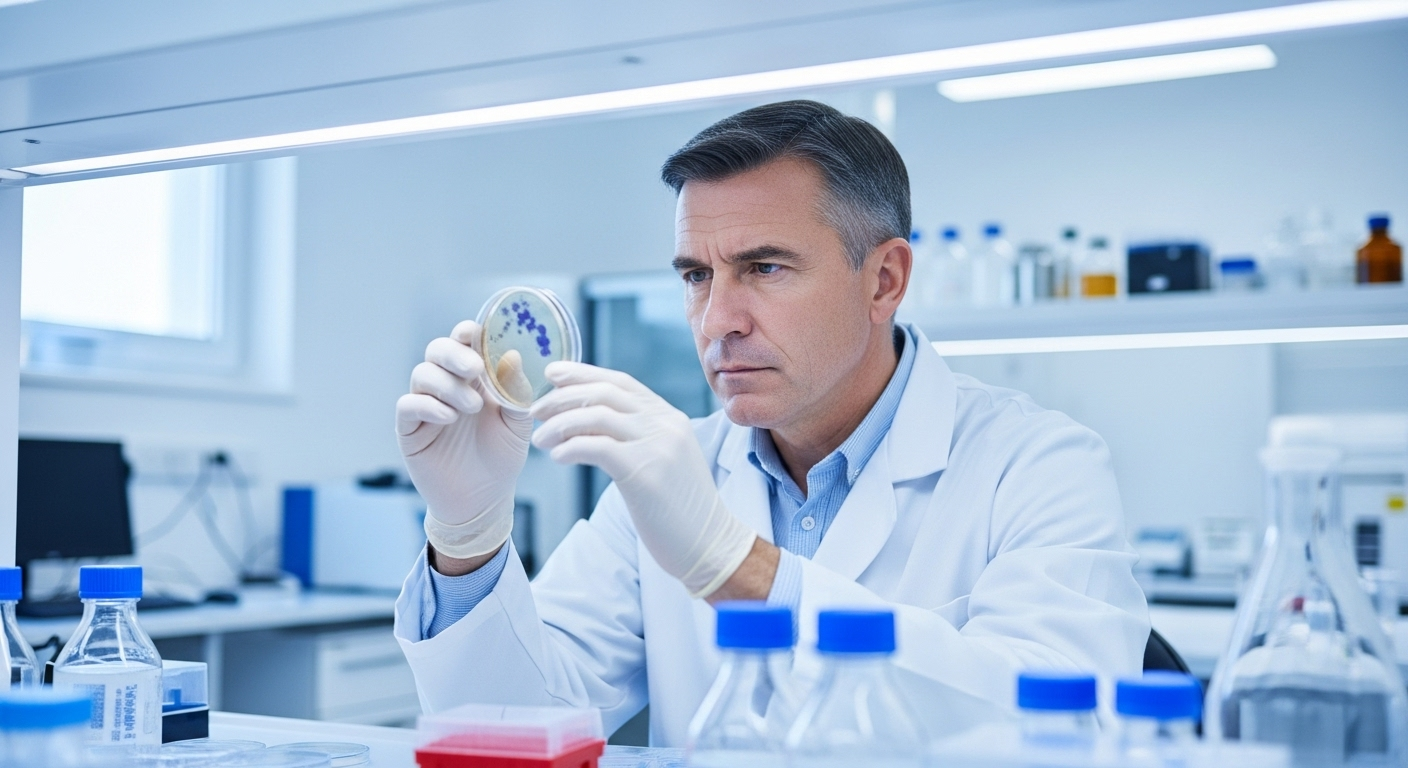

Qui aurait cru qu’un jour, on parlerait d’un simple sirop pour la toux comme d’un espoir potentiel pour lutter contre des maladies aussi redoutables que la démence ou la maladie de Parkinson ? C’est pourtant la piste très sérieuse qu’explorent des scientifiques. Une étude récente suggère qu’un ingrédient que beaucoup d’entre nous ont déjà pris pour soigner un rhume pourrait en fait avoir le pouvoir de ralentir la progression de ces maladies neurodégénératives. C’est une idée surprenante, presque trop simple pour être vraie, mais qui suscite un immense espoir dans le monde de la recherche.
Un ingrédient qu'on connaît tous : l'ambroxol

Cet ingrédient au nom un peu barbare, c’est l’ambroxol. Si vous avez déjà pris un sirop expectorant pour vous aider à dégager vos bronches, il y a de fortes chances que vous en ayez déjà consommé. Son travail habituel est de fluidifier les glaires pour nous aider à mieux respirer. Rien à voir avec le cerveau, a priori. Mais voilà, des chercheurs ont découvert que cet humble serviteur de nos poumons pourrait avoir une deuxième vie bien plus spectaculaire.
Comment ça marche, en termes simples ?

Pour comprendre, il faut s’imaginer que dans la maladie de Parkinson, notre cerveau a du mal à faire le ménage. Une ‘poubelle’ de protéines anormales (l’alpha-synucléine) s’accumule et endommage les cellules. Normalement, notre cerveau a sa propre équipe de nettoyage, une protéine appelée GCase. Le problème, c’est que chez les malades, cette équipe est moins efficace. C’est là que l’ambroxol entre en jeu : il agirait comme un super-stimulant pour l’équipe de nettoyage. En augmentant les niveaux de cette protéine GCase, il aiderait le cerveau à mieux évacuer ses déchets et donc, potentiellement, à ralentir la maladie.
Une première étude encourageante

Une petite étude a été menée au Royaume-Uni sur 55 patients atteints de démence liée à la maladie de Parkinson, pendant un an. Les résultats sont prometteurs, mais il faut rester prudent. D’abord, et c’est très important, le médicament a été bien toléré, sans effets secondaires graves. Ensuite, il semble avoir stabilisé les symptômes des patients, surtout chez ceux qui avaient une prédisposition génétique à la maladie. C’est un premier pas très encourageant.
Restons prudents : ce n'est pas un remède miracle
Il faut être honnête, cette première étude n’est pas la solution miracle que tout le monde attend. Les chercheurs eux-mêmes le disent : les résultats ne sont pas un ‘home run’ éclatant. Par exemple, il n’y a pas eu de grande différence sur la mémoire ou les capacités cognitives pour l’ensemble du groupe. L’effet semblait plus marqué chez certains patients, mais le groupe était trop petit pour en tirer des conclusions définitives. C’est un début, pas une fin en soi.
L'espoir est permis : des études plus grandes sont en cours

La bonne nouvelle, c’est que les scientifiques ne s’arrêtent pas là. Cette première étude a donné suffisamment de raisons d’y croire pour que des recherches beaucoup plus importantes soient lancées. Au moins trois grands essais cliniques sont en cours actuellement. Le plus grand d’entre eux va tester l’ambroxol sur plus de 300 personnes pendant deux ans. C’est seulement à l’issue de ces études que l’on saura si l’ambroxol tient vraiment ses promesses. Il faudra donc être patient.
Conclusion : une piste sérieuse à ne pas négliger

Alors, faut-il se ruer sur le sirop pour la toux ? Surtout pas ! Mais cette piste de recherche est l’une des plus excitantes de ces dernières années. Elle nous montre que des solutions peuvent parfois venir d’endroits totalement inattendus. Si les grandes études en cours confirment ces premiers espoirs, l’ambroxol pourrait devenir le premier traitement capable de réellement ralentir la destruction causée par la maladie de Parkinson. Ce n’est encore qu’un ‘si’, mais c’est un ‘si’ qui redonne beaucoup d’espoir aux malades et à leurs familles.
Selon la source : jamanetwork.com










